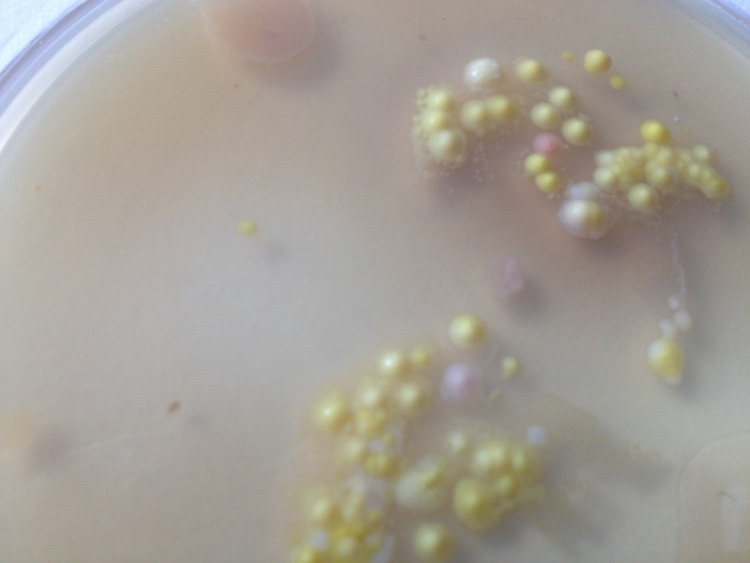
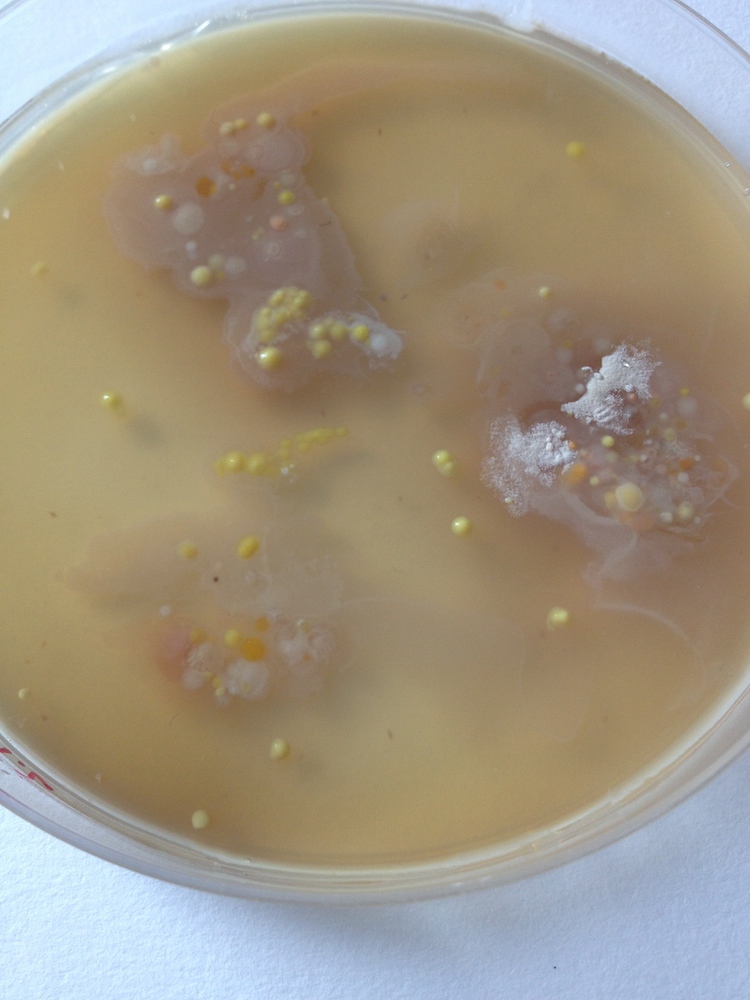
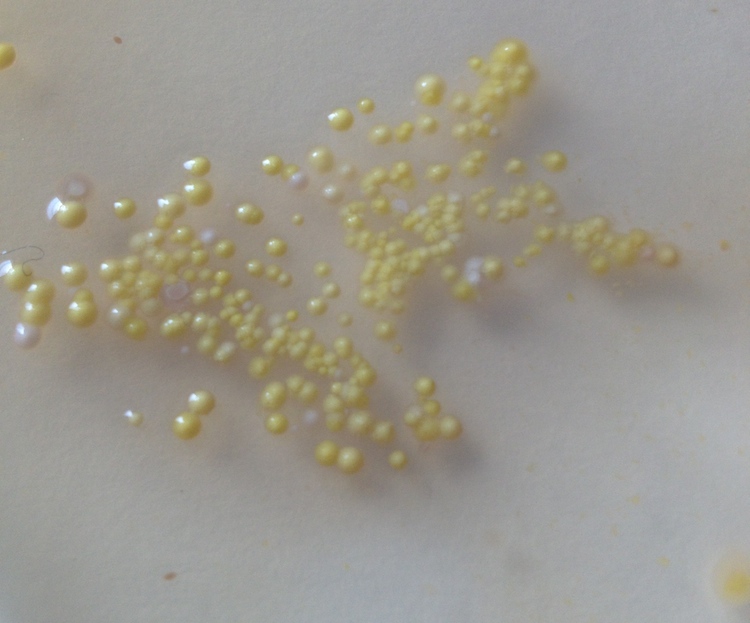
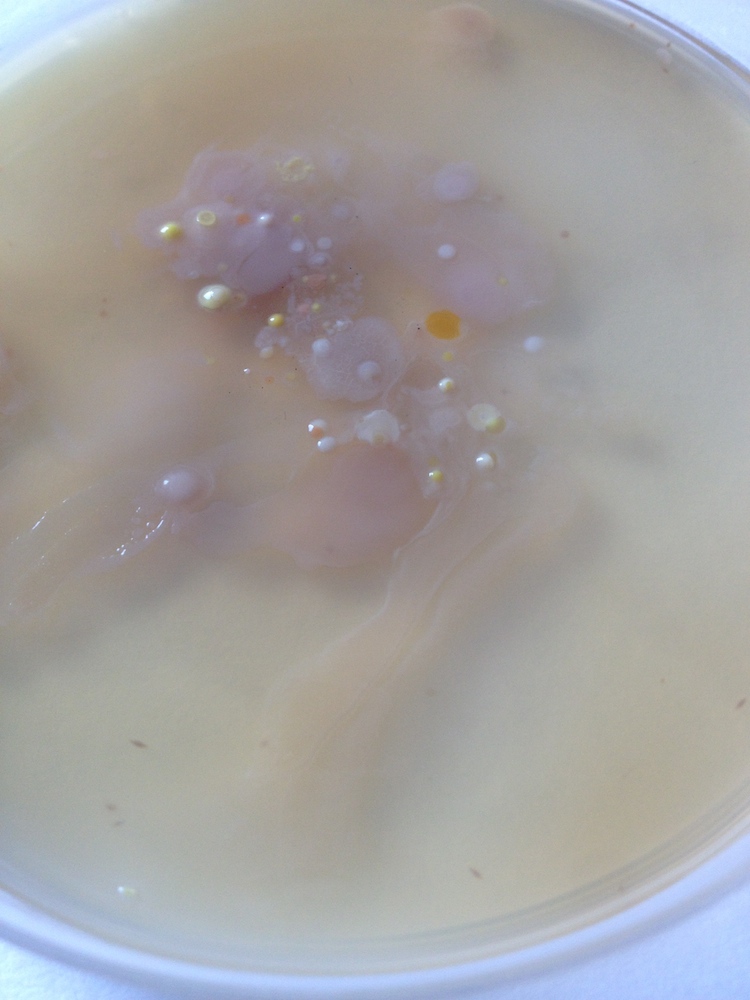

LOVE YOURSELF, OK? [1]
"love yourself, ok?" refers to our ambiguity towards our bodies and selfs. While worshiping and constantly trying to shape our bodies and minds towards a virtual ideal, we tend to forget about the sheer magnificence our bodies already provide.
The following questions are the starting point of my research, that I will document visually and in written form on http://http://uloveyourselfok.tumblr.com/ and via a daily live stream from mid february 2015 on.
What is a bacterium?
How do they work?
What do they need from us?
Why do we need bacteria?
Are we important to our bacteria?
How do they look like?
How do people imagine bacteria?
Should we fear our bacteria?
Should we love our bacteria?
If so, how can we show love to our bacteria?
While trying to answer all these questions I will provide visual evidence about my process and manufacture a diagram of my chosen „animal’s“ habitat. Parallel to that I will set up a DIY laboratory to provide myself with an in depth real life experience with my very own bacteria, that I am planning to let grow under ideal conditions and document the growing process via several media outlets, such as a live-stream http://www.ustream.tv/channel/loveyourselfok and photographs, illustrations and media alike to be able to show any kind of progress in the knowledge of my chosen subject.
1. Work in Progress diagram of bacteria//body Habitat
2. EXPERIMENT DAY 1
IMPRINTS on Luria Bertani Agar Miller
FIRST ROW:
FOREFINGER, RIGHT HAND
NEUTRAL, DISINFECTED, DIRTY (FLOOR)
SECOND ROW:
BALL OF THE HAND, RIGHT HAND
NEUTRAL, DISINFECTED, DIRTY (FLOOR)
2. RESULTS, AGAR PLATES with Imprints of right finger and ball of the hand in multiple states
1.0 FOREFINGER RIGHT HAND NEUTRAL
1.1 FOREFINGER RIGHT HAND DESINFECTED
1.2 FOREFINGER RIGHT HAND DIRTY (STUDIO FLOOR)
2.0 RIGHT BALL OF THE HAND NEUTRAL
2.1 RIGHT BALL OF THE HAND DESINFECTED
2.2 RIGHT BALL OF THE HAND DIRTY (STUDIO FLOOR)